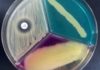
Bright Idea for Detecting Harmful Bacteria in Food Products

GATE 2022 – Answer Key Released, Download Master Question Paper & Compare
GATE 2022 Answer Key Released, Download Master Question Paper & Compare
Dear Candidates,
GATE 2022 Master Question Paper & Answer Keys has been released for GATE...
SGPGIMS PhD Program Admission 2022 (Session I), Applications Invited
SGPGIMS PhD Admissions 2022 - SGPGIMS Admission to PhD Program
Sanjay Gandhi Postgraduate Institute of Medical Sciences has been established under the State Legislature Act...
RCB Life Sciences Project-JRF Job Opening, Applications Invited Online
RCB Life Sciences Project-JRF Job Opening, Applications Invited Online
RCB Life Sciences Project-JRF Job Opening, Applications Invited Online. MSc Life Sciences Project-JRF Opening. Interested and...
MACS-ARI Pune Biotech & Microbiology JRF Recruitment
MACS-ARI Pune Biotech & Microbiology JRF Recruitment
MACS-ARI Pune Biotech & Microbiology JRF Recruitment. JRF jobs at MACS-ARI Pune. MSc Biotechnology and Microbiology JRF Job....
Biological Sciences Project Associate Job at ICMR-NIRRCH
Biological Sciences Job at NIRRCH, Online Application Process
Biological Sciences Job at NIRRCH, Online Application Process. NIRRH recruitment for PA vacancy. NIRRH National Institute for...
Ferrero Food Safety Executive Job Opening, Apply Online
Ferrero Food Safety Executive Job Opening, Apply Online
Ferrero Food Safety Executive Job Opening, Apply Online. BSc & MSc Food Technology Executive Food Safety Job...
Government ILS Bio-repository for COVID-19 Viral and Clinical Samples Project Recruitment
Govt ILS PhD Research Associate Recruitment In COVID-19 Project
Govt ILS PhD Research Associate Recruitment In COVID-19 Project. PhD life sciences candidates apply for RA...
IISER Pune Life Sciences Research Associate Job With Rs. 49,000 pm Pay
IISER Pune PhD Post - Life Sciences Apply
IISER Pune PhD Post - Life Sciences Apply. Research Associate Vacancy for PhD life sciences candidates. Interested...
Sharda University JRF Recruitment For MSc Biotech, Life Sciences
Sharda University JRF Recruitment For MSc Biotech, Life Sciences
Sharda University JRF Recruitment For MSc Biotech, Life Sciences. MSc Biotechnology / Life Sciences / Zoology...
Biotecnika Presents Concept Review Series For CSIR NET Life Sciences – 13 Days &...
Concept Review Series For CSIR NET Life Sciences - 13 Days & 13 Units
Ola dear Biotecnikans,
As usual, Biotecnika is back at it again with...
Calcutta University Life Sciences JRF Recruitment, Apply Online
Calcutta University Life Sciences JRF Recruitment, Apply Online
Calcutta University Life Sciences JRF Recruitment, Apply Online. MSc Life Sciences JRF Job. MSc Life Sciences Junior...
NIPGR MSc & MTech Bioinformatics Project Associate-I Recruitment
NIPGR Bioinformatics Project Vacancy Available, Apply Online
NIPGR Bioinformatics Project Vacancy Available, Apply Online. MSc & MTech Bioinformatics Project Associate-I job at NIPGR. Interested and...
SERB Funded Colorectal Cancer Project JRF For Life Sciences at NII
NII Delhi Project Vacancy Available, Applications Invited
NII Delhi Project Vacancy Available, Applications Invited. MSc Life sciences Junior Research Fellow (Project) job at National Institute...
NIMHANS HIV-Viral Load Project Tech Officer Recruitment
NIMHANS Technical Officer Job - HIV-Viral Load Project
NIMHANS Technical Officer Job - HIV-Viral Load Project. MSc in Microbiology / Biotechnology /Life Sciences technical officer...
CSIR-NCL Production Of Penicillin Project Associate Recruitment, Apply Online
NCL Pune Project Job - Associate Recruitment, Apply Online
NCL Pune Project Job - Associate Recruitment, Apply Online. NCL Pune is hiring BTech & MSc...